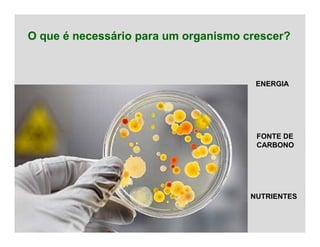
O que é necessário para um organismo crescer?
ENERGIA
FONTE DE
CARBONO
NUTRIENTES
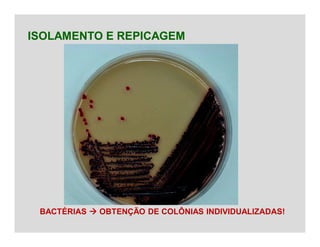
ISOLAMENTO E REPICAGEM
BACTÉRIAS  OBTENÇÃO DE COLÔNIAS INDIVIDUALIZADAS!

O documento discute a nutrição e o crescimento microbiano. Ele explica que microrganismos precisam de energia, carbono e nutrientes para crescer e se reproduzir. Detalha as diferentes fontes de energia e carbono utilizadas por micróbios autotróficos e heterotróficos e os principais nutrientes necessários, incluindo água. Também aborda os efeitos da temperatura, pH e disponibilidade de oxigênio no crescimento microbiano e descreve técnicas para cultivar micróbios, como meios de cultura